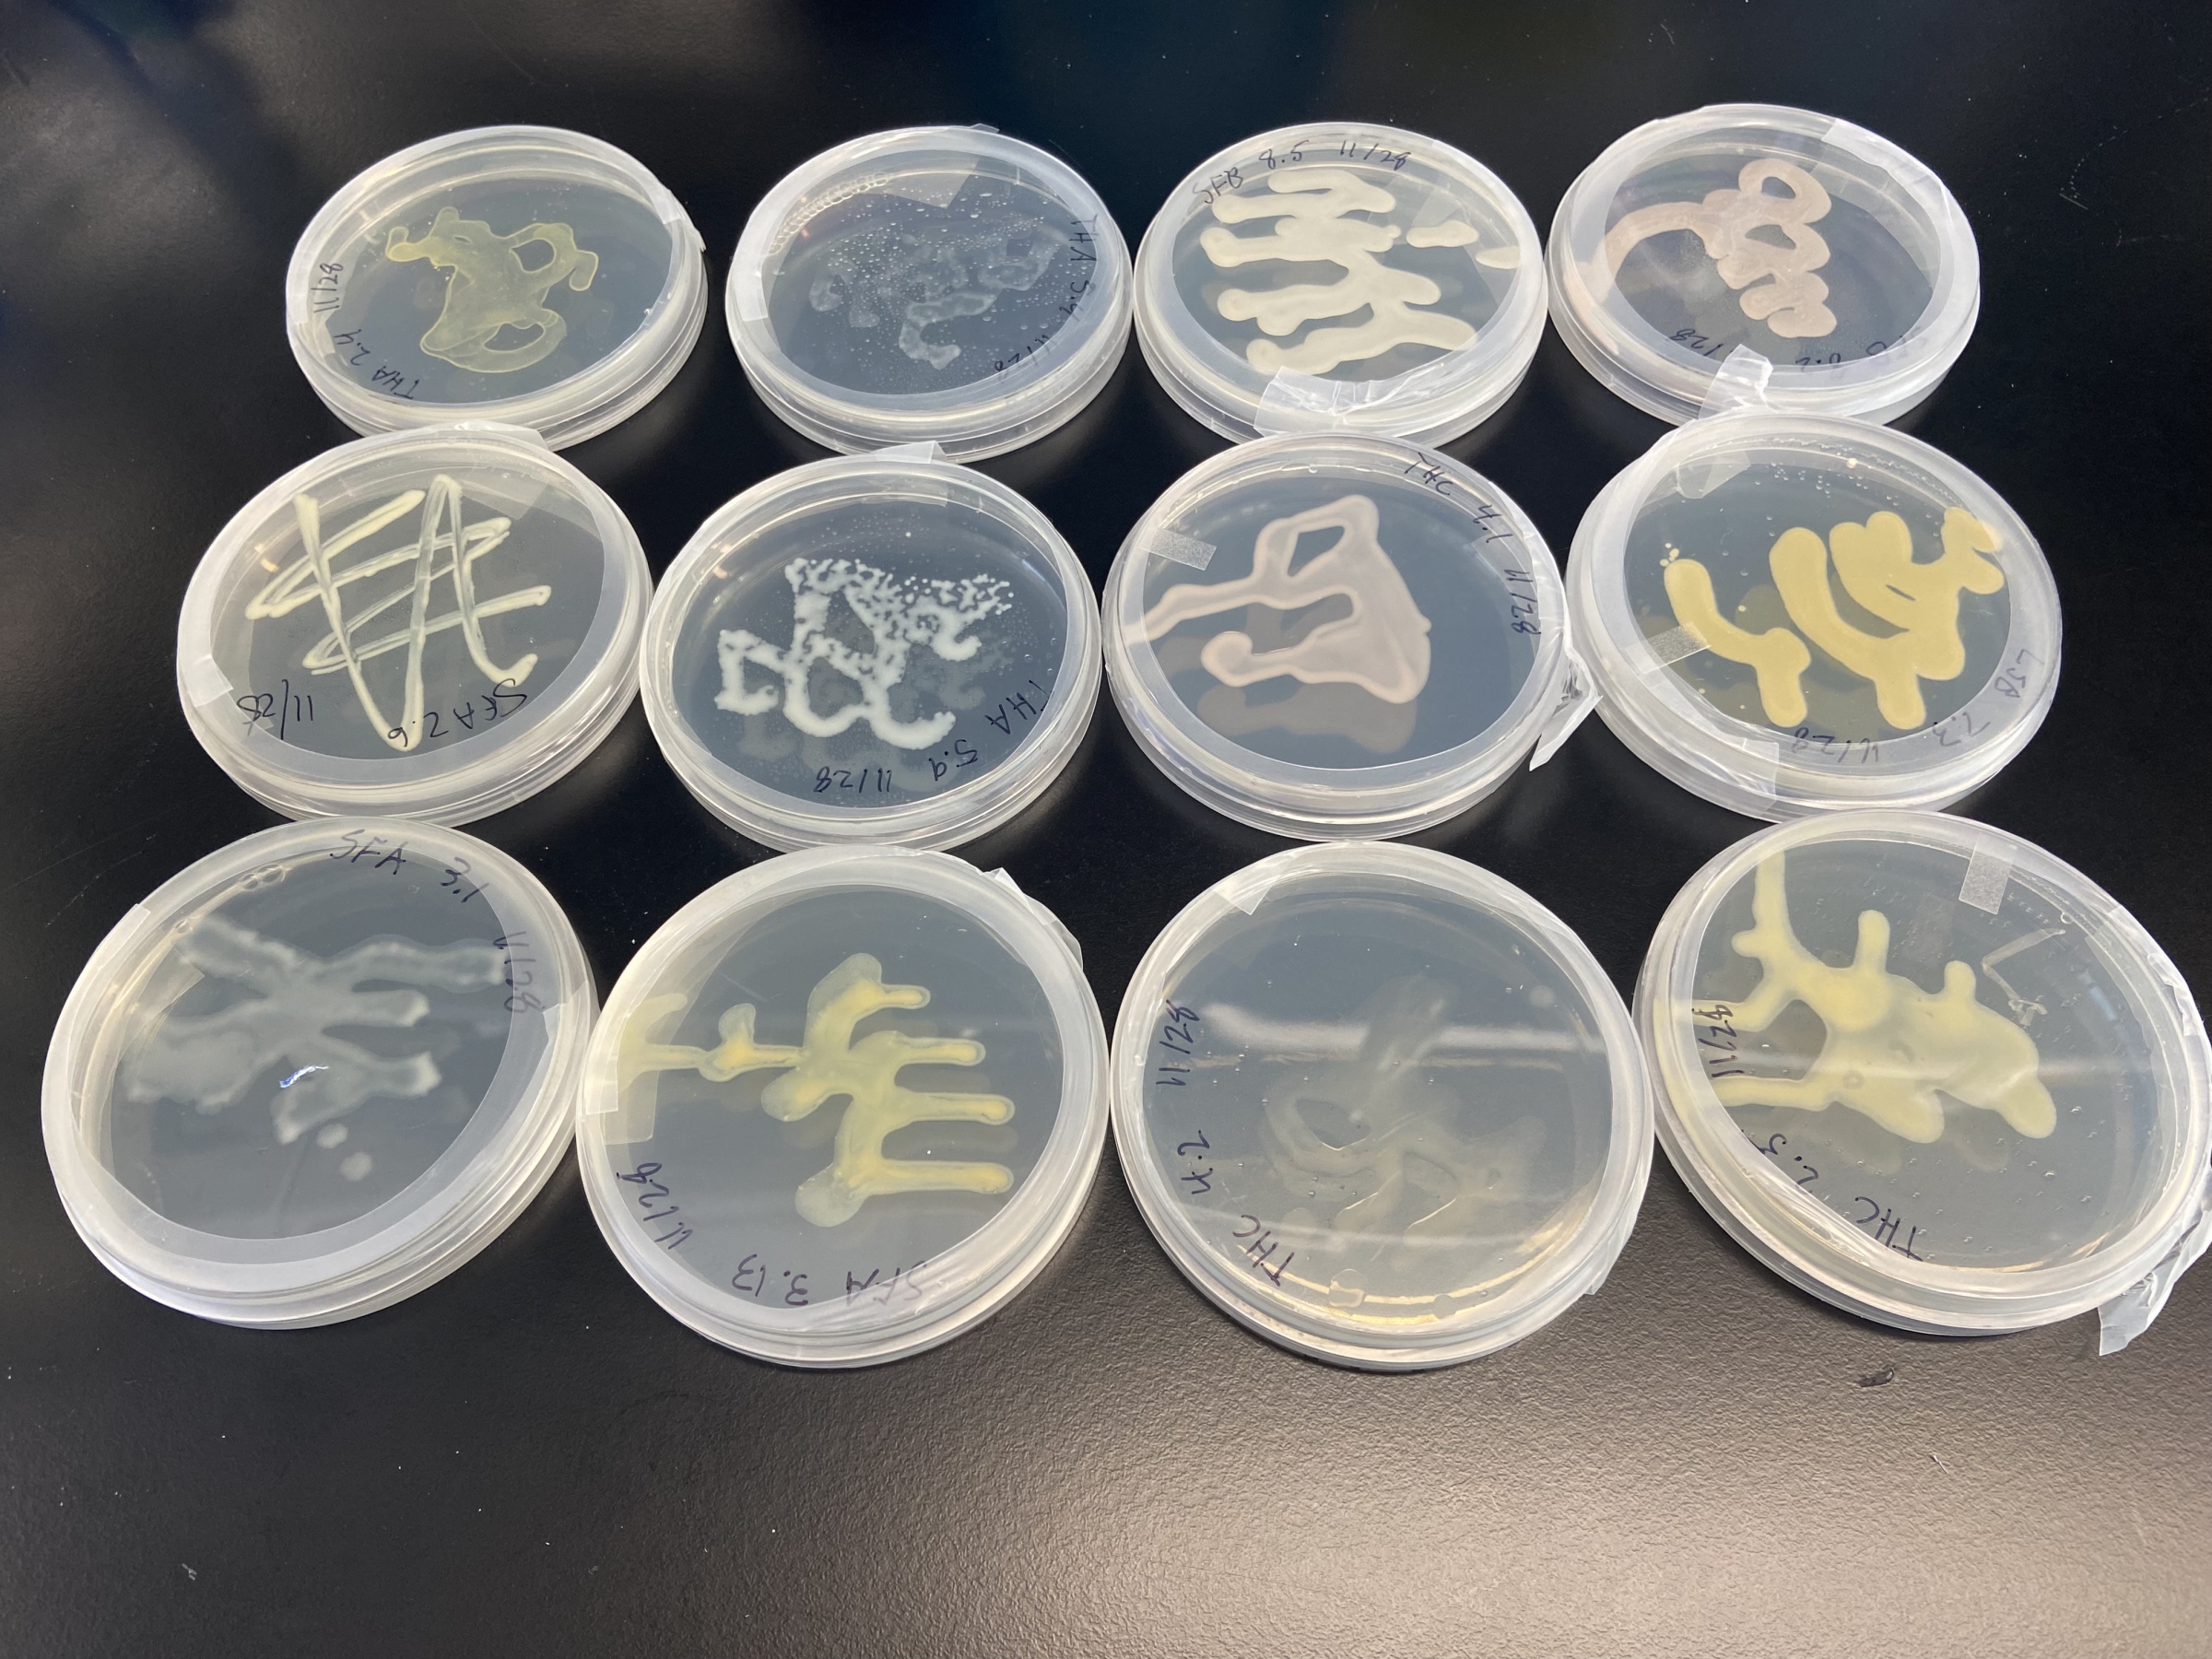
Image of a 12 petri dishes with various types of bacteria.

Carly Muletz Wolz looks at tiny microbes to answer big questions about our ecosystems

Carly Muletz Wolz catches eastern newts in a pond at Mountain Lake Biological Station in Virginia. The Appalachian region has the most species of salamanders in the world. Image: Courtesy Carly Muletz Wolz
What happens if a red wolf has a bellyache? What if a cheetah suffers from tummy troubles? At the Smithsonian’s National Zoo and Conservation Biology Institute (NZCBI), they call microbiologist Carly Muletz Wolz to investigate.
Muletz Wolz studies microorganisms such as bacteria and fungi that affect the health of plants and animals—in good ways and bad—and her colleagues often turn to her if they want to know if their animals’ GI issues have something to do with the microbes in their gut. But her expertise in microbiology leads her research in a lot more directions than just what is going on in an animal’s stomach. “I’m probably thinking about two or three different scientific questions at one time. Well, I try to only think about two or three,” Muletz Wolz explains.
“Microorganisms are everywhere,” said Muletz Wolz. “Because microbes affect so many systems, when I started at the Smithsonian, everyone came knocking at my door asking for help." That’s the power of understanding the “unseen majority,” as Muletz Wolz calls it, or put another way, “the things that grow in your fridge when you’ve left food there too long.” They’re on your skin, they’re in your mouth, they’re in the water, and they’re nested in soils. The group is made up of bacteria, viruses, fungi, and other microscopic organisms.
For one project, Muletz Wolz is looking at the soil of coffee farms. “Different farms manage their soils differently, and that impacts the quality of their coffee,” she said. “One question I’m asking is, how can we leverage the microbes in the soil to help farmers produce really high-quality coffee, while also giving trees to birds that are migrating through?”
While she studies all these questions about animals, plants, and soils for other scientists, Muletz Wolz also saves time to work on her first love: the slender-bodied, slimy, colorful amphibians we call salamanders.
As an undergraduate student, Muletz Wolz learned about large declines in amphibian populations around the world. The culprit appeared to be a fungus. “It seemed really interesting, and it seemed like an extra pressing concern. The more I thought about it, I got more excited about amphibian conservation,” Muletz Wolz explained.
As a first-generation college student, graduate school was never even part of the discussion for Muletz Wolz, but she knew she wanted to be involved in helping amphibians. “I went to college in my hometown of Frostburg, Maryland. The town’s population was about 7,000, and the university had about 4,000 students. I wasn’t thinking about going to Yale. I was just thinking of getting a degree,” she told us. So, when it came to continuing her studies of amphibians, Muletz Wolz knew what she wanted to do next, but she didn’t know exactly how to get it done. “I moved to Vermont without a plan. I was just figuring it out as I went. I didn’t get into the first couple master's programs that I applied to. It wasn’t an easy road,” she said.

Eventually, Muletz Wolz made it into James Madison University in the Shenandoah Valley of Virginia, an area that just happens to be ripe with salamanders. “For my masters, I studied probiotic bacteria we applied to their skin to protect them from the chytrid fungus [the fungus causing the amphibian decline], and it worked! I wish I could say it works for all amphibians, but it doesn’t. It works for some and not others. But our results made it really easy for me to decide that I wanted to do a Ph.D.”
Then came another choice: go to the school on the West Coast to experience a new environment and academic culture, or stay near family and a more familiar environment? “People always want scientists to move across the country and move their lives all the time. I considered it. I got into a program in Washington State, but I decided to stay on the East Coast.” Muletz Wolz ultimately landed at the University of Maryland, just 150 miles away from where she grew up and a 30-minute drive from her eventual employer, the Smithsonian’s National Zoo.
There, among her other work, Muletz Wolz is studying why most salamanders are highly resistant to the fungus that’s killing off frogs. This is vital work for amphibian species—in 2023, NZCBI colleague Brian Gratwicke, along with co-authors, showed that over 40 percent of amphibians are under threat of extinction. “We want to know what [salamanders] make, or what their immune systems have, that protects them from this pathogen,” Muletz Wolz said.

Staying close to home all this time has given Muletz Wolz’s work a new layer of meaning for her. “I like to study local species. I study Appalachian salamanders. We have more species of salamanders than anywhere else in the world, and I feel very proud of that. Glaciers moving in and out of this area led to all this really rich biodiversity in salamanders over the years, and I think they're really beautiful. They come in all different shapes, sizes, and colors. I can go to my backyard in College Park, Maryland, and find [Eastern] red-backed salamanders. You can hold them in your hands. I think they're just incredible.”
Besides the fact they look cool and that we can hold them in our hands, why should we care about salamanders and other amphibians? “They eat mosquitoes,” Muletz Wolz quickly replied. “That’s usually enough for people.”
Muletz Wolz’s work exposes her to many different areas of nature, which allows her to appreciate its complexity. From the microbes on salamander skin to those in a cheetah’s gut to those in the soil of coffee plants, her passion shows through as she works to tackle the effects of climate change and protect biodiversity around the planet.
If you live somewhere between the Great Lakes region and Nova Scotia and you’re interested in finding salamanders in your backyard, check out this article from Muletz Wolz with tips.